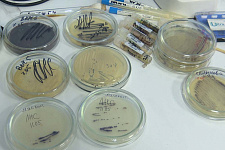

«Инкубатор технологий» объединил более 50 студентов из разных вузов России
Программа школы молодых исследователей рассчитана на повышение квалификации для студентов, магистрантов и молодых учёных.
Работу бесплатной школы «Инкубатор технологий» организовали при содействии студенческого научного общества НИУ «БелГУ». Интенсив включал теоретический и практический курс введения в мир науки. Слушатели школы изучали в том числе основы проектной деятельности, а на итоговом заседании круглого стола «Наука будущего: проекты и перспективные направления», который прошёл на базе НОЦ «Ботанический сад НИУ «БелГУ», участники выступили с докладами и презентациями проектов, которые уже участвовали в каких-либо конкурсах, либо являются перспективными для реализации.
Модератор мероприятия – директор института фармации, химии и биологии Андрей Присный – положительно высказался о представленных проектах, большая часть которых ориентирована на реализацию в Белгородской области.
Интересную разработку представила студентка 4 курса института фармации, химии и биологии Анастасия Кобелева. Её проект направлен на разработку состава и технологии раневого покрытия на основе хитозана. Изобретение могло бы быть полезно как в гражданской, так и в военной медицине. Как пояснила Анастасия Кобелева, хитозан получают из панцирей ракообразных. Материал является гипоаллергенным и достаточно доступен по цене. Аналогов разработки на российском рынке нет.
Магистрантка института фармации, химии и биологии НИУ «БелГУ» Татьяна Нужных для определения количества биологически активных веществ в разных сортах тыквы самостоятельно вырастила плоды пяти сортов и сравнила их состав. Как пояснила автор эксперимента, от идеи купить тыкву в магазине она отказалась, поскольку опытные образцы в таком случае были бы выращены в разных условиях и на разной почве. Исследование ориентировано на белгородцев, которые выращивают тыкву самостоятельно и хотели бы определиться с наиболее полезным сортом в свежем и переработанном виде.
Также участники представили исследования, посвящённые ассортименту лекарственных средств от сахарного диабета, замене продуктов животного происхождения в рецептах для веганов, запасу питательных веществ в корневищах дикорастущих ирисов и отличиям между термостатной и резервуарной кисломолочной продукцией.
О важности подобных мероприятий и развития студенческих стартапов рассказала начальник отдела научной и инновационной работы студентов и молодых учёных Ярослава Павлюк. Она отметила, что каждому проекту необходимо чёткое оформление, после которого он проходит несколько ступеней развития. Если всё сделано правильно, то стартап становится успешным, а его реализация приносит прибыль и решает поставленную задачу.
– Молодым учёным важны подобные мероприятия, потому что на них компании и начинающие предприниматели обсуждают и дорабатывают свои проекты с экспертами, разбирают сильные и слабые стороны своих разработок и продуктов, погружаются в тонкости рынка, в котором они стремятся развиваться. Также параллельно осваивают новые инструменты для работы над идеями и их реализацией, – подчеркнула Ярослава Валерьевна.
Спикер добавила, что образовательный интенсив «Инкубатор технологий» организован в рамках выигранного студенческим научным обществом гранта. В ближайшее время планируется ещё ряд подобных мероприятий, четыре из которых будут международного уровня.
Участники школы молодых исследователей получили сертификаты. После окончания заседания гостям мероприятия организовали экскурсию по территории ботанического сада НИУ «БелГУ».
06.06.2022
| << Назад к списку | | Просмотров: 1592 |
Войти, чтобы оставить комментарий.